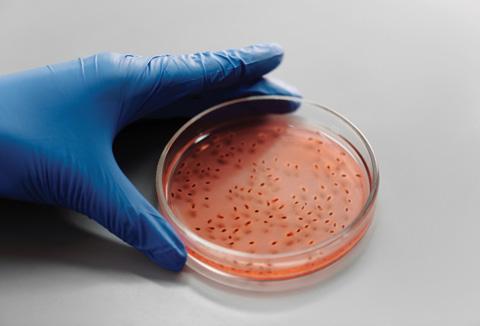

EANS
CNE pts: 5
演講內容:
‧ 高血壓
‧大灣區護理管
理高質量發展
‧精神科
演講嘉賓:


香港護士年會2024:香港基層 醫療健康發展暨大灣區護理前瞻
由護協專業發展基金贊助
‧糖尿病
‧ 心臟病
‧ 香港基層醫療 健康新發展
朱賢文博士 (香港都會大學護理及 健康學院高級講師)
彭剛藝教授 (廣東省護士協會會長)
李樹明先生 (精神科護士)


鍾巧儀博士 (聖雅各福群會深水埗地區康健中心總護理統籌主任)
姚秀芝女士 (心臟科顧問護師)
唐華根博士 (醫院管理局總護理行政經理)
<排名不分先後>
26/10/2024 (星期六),早上9:00 - 下午5:00
九龍油麻地窩打老道23號城景國際酒店2樓水晶殿
$350 (會員早鳥優惠,於2024年7月31日或之前報名)
$400 (會員) $800 (非會員)
* 費用已包括早、午茶點及自助午餐

Aromatherapy is generally defined as the skilled and controlled use of essential oils (pure essences from plants) to promote physical and emotional well-being. In the past century, it has evolved to become one of the major complementary therapies in many parts of the Western world (e.g. UK, France, Germany, the US, Australia etc), with evidencebased clinical applications well documented in hospices, clinics and hospitals that uphold natural holistic therapies.
The certificate course aims to:
• Nurture in participants an appreciation for and a basic understanding of aromatherapy, the advantages and medicinal properties of 20 commonly used essential oils and 6 base oil /base materials, and the ways to blend and apply them in our daily life.
• Develop in students a commitment to leading a more natural and healthier lifestyle, and pave the way for further study in clinical aromatherapy and other related disciplines.
* Course details have been shown on the registration link
Ms. Dawn Chan (陳德岫小姐) – Full Member of the International Federation of Professional Aromatherapists (UK), Professional Member of The National Association of Holistic Aromatherapy (USA), Associate Member of the American Herbalist Guild (USA)
7/8/2024 to 11/9/2024 (Wed, total 6 sessions), 7:00 -10:00pm 6/F, Parkes Commercial Building, 29-31 Parkes Street, Jordan, Kowloon
$1,500 (member) $1,800 (non-member) (Including course material fee)
*Certificate










CNE pts: 2.5
腦神經及兒童原始反射治療:自閉症譜系障 礙、發展遲緩及特殊學習需要兒童 Special Educational Needs, SEN (進階班:1)
此講座讓學員更深入了解最新功能性腦神經治療研究(Functional Neurology) 、「大腦重塑治療」及「兒童原始反射治療」方面。教授及示 範「針對性腦重塑運動」及簡單檢測孩子原始神經反射是否殘留。詳述如 何從「大腦重塑治療」、「無藥治療」、「腦重塑運動」、「原始反射整 合運動」及「飲食方法」解決自閉/社交/學習/認知/情緒行為/不專心及發展 遲緩問題。
課程內容:
‧ 從功能性腦神經瞭解腦神經發展的問題:自閉症、發展遲緩、過 度活躍/專注力不足、學習/讀寫問題、SEN
‧ 如何快速自我檢測左右腦功能有否失調
‧ 示範「針對性腦重塑運動」及「原始反射整合運動」
‧ 如何快速測試嬰幼童有否腦神經發展遲緩及自閉的問題
‧ 教授從觀察及簡易測試孩子有否腦部發展及原始反射殘留的問題 ‧ 教授如何從「爬行姿勢」觀察有否腦神經發展的問題
‧ 剖析殘留兒童原始反射發如何影響認知/語言/情緒行為/專注/學習/ 社交及體能
‧ 講解腦功能失調與自閉/發展遲緩/過動及學習困難之關係 ‧ 概述與自閉症/發展遲緩/ SEN相關的兒童原始反射
‧ 重金屬及飲食如何影響大腦發展、學習及智能?
‧ 概述如何檢測大腦功能、腦重塑治療、腦重塑運動、原始反射整 合運動及健腦飲食法

李憲嚴 - 脊骨神經科醫生 - 美國脊醫腦神經專科資格(Diplomate of American Chiropractic Neurology Board, DACNB) ,美國脊骨神 經科醫學博士(Doctor of Chiropractic, DC),香港註冊脊醫
30/7/2024 (星期二,共一節) 晚上6:30 - 9:00
九龍佐敦白加士街29 - 31號嘉士商業大廈6樓
$200 (會員) $300 (非會員)
* 完成課程者,可享有腦神經評估$500折扣優惠(出示收據證明) * 學員未有初班知識亦可以報名進階班 (1)
US
精神分裂症的認識 CNE pts:7.5
節數 / 日期 / 時間 內容
1) 4/7/2024 (星期四) ‧ 精神分裂症是什麼
晚上6:30 - 9:00 ‧ 精神分裂的成因及徵狀 ‧ 臨床個案分享
2) 11/7/2024 (星期四) ‧ 精神分裂症的診斷 晚上6:30 - 9:00 ‧ 治療方法及預後症狀 ‧ 臨床個案分享
3) 18/7/2024 (星期四) ‧ 精神分裂症之照顧技巧 晚上6:30 - 9:00 ‧ 與精神分裂症患者之溝通技巧 ‧ 臨床個案研究
精神科註冊護士 九龍佐敦白加士街29 - 31號嘉士商業大廈6樓
$780 (會員) $880 (非會員)
* 本會將於課程完結後發出證書予完成整個課程之學員
20 專 業 發展 及 持 續 教育部課程 慶雲4樓 2314 6911
NMA
of Attendance will be awarded for attendance in not less than 80% of the sessions Understanding Aromatherapy CNE pts:18 UAT
會員網上報名: 1 https://eahkns.nurse.org.hk/Courses 2 掃描本頁QR Code




CNE pts: 3
















此課程由香港復康會適健中心及香港護士協會合辦
透過體驗班,我們可以讓你對催眠治療及心理輔導如何處理腸胃焦慮 症所帶來的問題有初步的認識。同時為你解構情緒困擾與腸胃焦慮症 的相關性及如何運用催眠技巧去消除腸胃焦慮症的癥狀。
黎詠雅小姐 - 註冊催眠治療師、註冊社工 9/7/2024 (星期二,共一節) ,晚上6:30 - 9:30
九龍佐敦白加士街29 - 31號嘉士商業大廈6樓
$320 (會員) $420 (非會員)
FABW
內容:
流體熊仔工作坊
‧ 認識流體畫
‧ 製作流體熊技巧
魏先生 - 多年教授流體畫經驗
28/6/2024 (星期五) , 晚上7:00 - 8:00

九龍佐敦白加士街29 - 31號嘉士商業大廈6樓
$300 (會員) $400 (非會員)
人數:20人


*人數:20人 (每班人數若不足6人將會取消)
*成品:23cm流體熊仔x1 (成品風乾需時, 請於2/7取回)
*完成工作坊可獲$100護協現金禮券 (需購滿指定金額)
截止報名日期: 14/6/2024
女子成人游泳班 FST
課程由Splash Aquatic Centre 提供
A班 (逢星期二)
B班 (逢星期五)

6月4日至7月23日 (共八堂),晚上7:30-8:30
6月7日至7月26日 (共八堂),晚上7:30-8:30
C班 (逢星期二及五)
6月4日至6月28日 (共八堂),晚上7:30-8:30
$1,300元 (會員) $1,400 (非會員)
九龍公園泳池
* 請自備毛巾、泳鏡、泳衣、入場費 (成人$19) 及一枚5元硬幣作儲物櫃之用 炎炎夏日,游泳必然是夏天 最佳選擇。由前港隊女泳員 Anson主理泳班,既可紓緩 壓力、舒展筋骨,又能夠加 強心肺功能,對抗疾病。
* 由女教練任教
* 費用已包括浮板、水袖輔助用品

CPTH2065EP- 195
CNE pts:8
Contents:

會員網上報名:






“Certification of Achievement” will be awarded for attendance not less than 70% of the sessions. CNE points of these short courses will be provided by HKMU LiPACE.
Venipuncture and Blood Taking Technique
• Provide theoretical knowledge on venipuncture and blood taking for health care professionals
• Provide preventive measures for possible complications of intravenous insertion and infusion
• Enhance the participant’s skill on relevant aspect by demonstration and on-hand practice
Experienced Health Care Professional in Phlebotomy
22/5/2024 - 12/6/2024 (Wed, total 4 sessions) 7:00 – 9:00pm
6/F, Parkes Commercial Building, 29-31 Parkes Street, Jordan, Kowloon
$1,300 (member) $1,400 (non-member) (including course material fee)
品酒是一場美妙的旅程,讓我們共同享受這個迷人的酒文化! 課程 將帶領您深入了解葡萄品種、產區差異、酒的製作過程以及專業 的品酒技巧。透過互動的學習和實際品味,您將能夠培養出優雅 的品酒能力,更好地欣賞並選擇適合自己口味的美酒。
內容:
‧ 品酒鑑賞技巧
‧ 品嚐三款紅酒: Canadian Vineland Cabernet Franc 2020, Spanish Las Cuadras Tinto 2019, Spanish Livius Garnacha 2008
‧ 品嚐三款白酒: Canadian Vineland Chardonnay 2021, Spanish Las Cuadras Blanco 2019, Italian Roero Arneis DOCG 2020
‧期間會有小食提供
曾張麗華女士 - 紅白酒專家
14/6/2024 (星期五,共一節),晚上6:30 - 8:30
九龍佐敦白加士街29 - 31號嘉士商業大廈6樓 $150 (會員) $250 (非會員)
*參加者必須年滿18歲





21 慶雲4樓 2314 6911 專 業 發展 及 持 續 教育部課程
HTGA 『催眠治療』臨床應用體驗班 – 腸胃焦慮症
1 https://eahkns.nurse.org.hk/Courses 2 掃描本頁QR Code
Sponsored by Suburfarm Investment & Trading Co. Ltd.
Wine Tasting Workshop
WTW











































































































MASTER OF PUBLIC HEALTH (MPH)

CityU is an innovative hub for research and education #70 [QS] World University Rankings 2024


UGC Fellowship opportunities for local students HK$120,000 each



Programme Leader
Prof MING Wai Kit
wkming2@cityu.edu.hk
General Enquiries
ph.tpg@cityu.edu.hk


< Advertisement>
2-year part-time 1-year full-time

Research Training (RT) Stream
Curriculum: Master of Public Health (30 credit units)
The Master of Public Health (MPH) programme is divided into two streams: the Research Training Stream and the Practicum Stream.
The Research Training Stream is designed for students who wish to focus on developing advanced research skills and knowledge, particularly those considering future doctoral study. On the other hand, the Practicum Stream is geared towards students who wish to gain practical experience in the field of public health, providing opportunities for experiential learning in professional settings.
Students are required to complete 30 credit units for graduation from this Master of Public Health (MPH) programme.

Practicum Stream
Core Courses (18 credit units)
• Introduction to Health Economics and Outcomes Research
• Basic Biostatistics in Public Health
• Fundamentals of Epidemiology in Public Health
• Environmental Health and Risk Assessment
• Advanced Epidemiology
• Infectious Disease Epidemiology Elective Courses
• Statistical Data Analysis
• Statistical Modelling for Data Mining
• Time Series Analysis
• Spatial Data Analysis
• Public Health Surveillance
• Computational Biology, Experimental Design and Data Science
• Communication Skills - Conference Organisation
• Intermediate Level Statistics for One Health


Application
Interested applicants can apply for admission directly through the https://www.cityu.edu.hk/pg/programme/p96
Application Period
Application for 2024-25 entry is now open. Please visit https://www.cityu.edu.hk/pg/programme/p96 to obtain more information about the application process.
Selection Criteria
Selection will be based on the applicants’ undergraduate qualifications and, if necessary, the interview results.

< Advertisement>
Compulsory Core Courses credit units
Applied Public Health credit units
Elective Courses credit units
Compulsory Core Courses credit units 18 Practicum credit units 6 Elective Courses credit units 6 It is a matter of discretion for individual employers to recognize any qualification to which this course may lead.
18
9
3
(Clinical Leadership)
Western Sydney University, one of the largest universities in Australia, is a national leader in nursing and midwifery education, research and scholarship, with one of the largest undergraduate pre-registration nursing degree courses in Australia.
In a successful and rewarding collaboration with Western Sydney University since 1991, the School of Continuing Education, Hong Kong Baptist University has o ered Bachelor’s and Master’s degree programmes in health care, and now over 4,600 professional participants have graduated.
THE PROGRAMME
The programme is uniquely designed for nursing professionals to develop their leadership capacity in a manner that enables them to implement transformative change while maintaining nursing excellence within the clinical practice environment.
Information Seminar
Date : 24 May 2024 (Friday)
Time : 6:30 - 7:30 pm
Venue : Vir tual M
Speakers : Professor Associate D
Professor Lucie Ramjan Director of
Please visit our Programme



<Advertisement>
PROGRAMME STRUCTURE (80-CREDIT-POINT PATHWAY)
The Master of Nursing (Clinical Leadership) consists of 7 subjects, totalling 80 credit points. Each subject is normally in the form of 18-hour face-to-face lectures and tutorials, supplemented by a comprehensive set of self-learning materials and resources. The programme structure is summarised below:
ADMISSION REQUIREMENTS
1. Applicants must:
l be a Registered Nurse (currently registered with the Australian Health Practitioner Regulation Agency –Nursing and Midwifery), or eligible for same, or certificate of registration of nursing, within the last 5 years, in their own country;
l have 2 years of full-time equivalent work experience as a Registered Nurse or Registered Midwife within the last 5 years*; and
l have completed an undergraduate degree in health-related sciences (AQF Level 7 or equivalent), in health science, human science, midwifery, naturopathy, nursing, nutrition, psychology OR have completed a Graduate Diploma in Nursing (AQF Level 8 or equivalent), or higher, in a health-related discipline.
2. Applicants should possess an appropriate level of English proficiency and may have to provide documentary evidence as deemed necessary.
* Applicants with less than 2 years of full-time equivalent work experience will be enrolled into the 120 credit-point pathway.
PROGRAMME FEE
The tuition fee of the programme is HK$14,300 per 10 credit points for the 2024/25 academic year that is to be paid in instalments on a term basis.
APPLICATION DEADLINE
Application deadline for admission is 7 June 2024. The application will be processed immediately upon receipt of the application form.
COMMENCEMENT

October 2024
any qualification to which this course may lead. Exempted
Subject Credit Points Leadership in Clinical Practice (NURS
10 Cultural & Social Diversity in Health Care
10 Evidence-based Health Care (NURS
10 Leadership for Quality and Safety in Health Care (PUBH 7018) 10 Building Organisational Capacity in Health Care (HLTH 7002) 10 Policy, Power & Politics in Health Care Provision (PUBH 7020) 10 Capstone Experience in Health Care
20 hkbusce.hk/mncl 3411 4305 gpsuws@hkbu.edu.hk P24010007_MNCL AHKNS_insert
It is a matter of discretion for individual employers to recognise
Course of Non-local Courses Registry, Education Bureau (Reference Number: 411834, 411835) WSU CRICOS Provider Number: 00917K The School reserves the right to make alterations without prior notice.
7028)
(NURS 7019)
7023)
(NURS 7065)